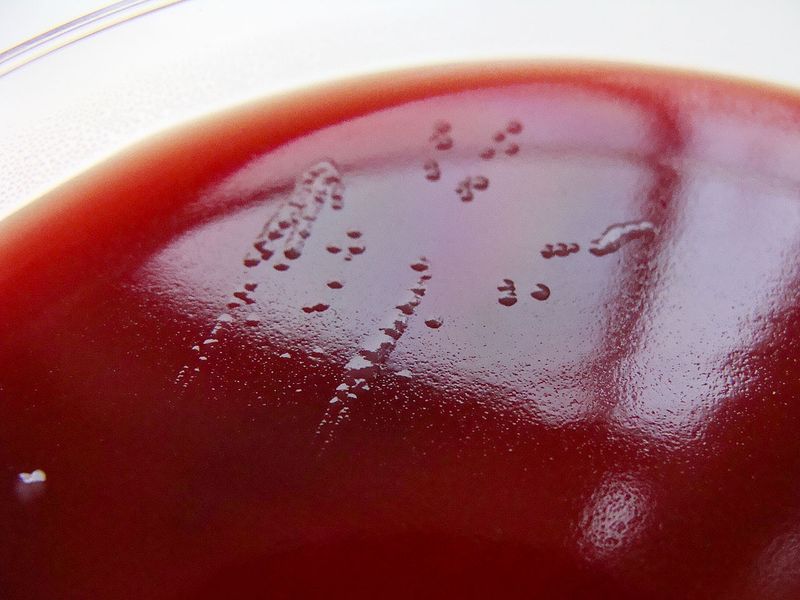

每个人都会放屁。每人每天放屁可达到10至20次。但就是这样一件稀松平常的事情中也有许多你不知道的小知识。
【1】你的身体每天会产生500至1500毫升气体,并通过10至20次放屁将其排出
这个数据可能比你想的要多,但这是试验研究所得出的结果。据梅奥诊所(Mayo Clinic)研究肠道微生物的胃肠病学家Purna Kashyap说,这是人体结肠内的微生物导致的。
他说:“我们会吃下许多碳水化合物(主要存在于蔬菜、谷物和水果中),而我们的身体内却没有必要的酶对其进行消化。这些碳水化合物最终到达大肠,这里的微生物会通过发酵将其分解,用以补充自身能量。而气体则是这一过程的副产品。”
许多食物中都含有这种人类无法完全消化的复合糖,例如几乎所有的豆类、大部分蔬菜,以及所有全麦食物。这会导致大多数人身体内每天产生500至1500毫升气体——相当于1升苏打水的含气量。

【2】人体体内产生的99%气体都没有气味

我们之所以没有料到自己的体内居然会产生如此多气体,是因为几乎所有气体都没有气味。
人体大肠中所产生的气体中,99%都是氢气、二氧化碳和甲烷。这些气体都没有气味,所以大部分时间里,人们并没有闻到屁的气味。
研究发现,之所以有的屁会恶臭难闻,是因为其中含有1%的硫化物,如氢化硫等(这个研究本身就令人瞠目结舌:试验者将曾吃过花豆的16个人的屁用“气密聚脂薄膜裤”收集起来,让两个人来对这些屁味进行判断)。
尽管并不是所有含有碳水化合物的食物中都有硫,但是有许多食物确实是这样子的。或许你早已将这些食物与放屁联系起来了:诸如豆类、洋葱、菜花、孢子甘蓝、西兰花、奶制品等。

【3】口香糖和苏打水可以使人体产生更多的屁
除了细菌产生的气体之外,相当一部分胃肠胀气是由人体自身吸入空气所造成的。这部分气体大多是氮气和氧气,所以并没有任何气味。部分气体是人在睡眠时所吸入的,但是,饮用碳酸饮料、嚼口香糖会大大增加人体对空气的摄入。
【4】放屁是由肠胃中健康且复杂的生态系统所造成的
现代社会很鄙视放屁。但是事实上,放屁其实是美好事物——肠胃中细菌的复杂生态系统——的副产品。
Kashyap说:“那是一种十分复杂的生态系统,各种有机体共同生活,共同成长。当复合糖到达人体结肠时,一些细菌会首先将其分解,该过程所产生的副产品又为其他细菌所吸收。所有细菌都得益于人所食用的单糖。”
除此之外,人体自身也可以从单糖中获益。科学家们认为,微生物在人体消化中所产生的作用无与伦比。产生气体的细菌同时也会产生维生素和脂肪酸,对结肠和免疫系统有极大益处。
【5】人往往不介意闻到自己的屁味,这是有原因的
试验证明,与别人的屁相比,我们常常不介意闻到自己的屁。
原因是:我们已经习惯了长时间围绕在自己身边的气味。这就是为什么当你走入陌生人家里时会闻到明显的气味,但却经常闻不到自己家的气味。
这也是为什么你已经习惯于体内细菌所产生的混合气味,而每个人的屁味都不太一样。所以,即使别人会觉得你的屁味恶臭难闻,但是你却并没有这种感觉。
【6】你可以用火点燃自己所放的屁
因为人体胃肠胀气的组成部分包括诸如甲烷、氢气等可燃气体,所以屁其实是可以短暂点燃的。
但是由于这种行为具有很大风险,所以我们并不建议这样做。

【7】人无法憋屁
这句话的道理其实很明显。但是出于各种原因,人们还是对这个问题充满好奇心。有时候,将屁憋住一小会之后,屁就会慢慢消失。
但是事实上,这并不可能。你之所以觉得屁在慢慢消失,其实是因为你已经无法感觉到屁的存在。但是屁仍然在慢慢地从人体体内释放。屁其实是气泡,除了从肛门中排放以外,它并没有其他地方可以去。
【8】Beano通过饿死大肠内的细菌,减少屁的排放
Beano是一款帮助人们停止放屁的药物,它的效果确实和广告中说的一样:“在放屁之前让屁消失”。试验发现,吃过满是豆子的食物后,Beano确实可以减少大肠内细菌所产生的气体。
原理其实很简单:Beano药片中含有α-半乳糖苷酶(alpha-galactosidase),这种酶可以将复合糖转化为更容易为人体所吸收的糖。如此一来,这些糖就会在人体小肠中进行分解,而无法到达大肠、被细菌吸收而产生气体。
然而,习惯性服用Beano来阻止气体产生也有其坏处。

【9】饿死大肠内产生屁的细菌其实并不是一个好主意
Kashyap说,大部分人其实并没有必要去主动限制气体产生量。所产生的气体其实是肠道细菌与饮食相平衡的结果。除非你有胀气等其他病,否则最好不要胡乱插手人体生态系统。
“对很多人来说,首先想到的就是不吃导致气体产生的食物。但是这些含有复合糖的食物是大肠内细菌的营养品。除非事出有因,否则不要随便饿死这些细菌。”
除此之外,他还说,许多人认为自己产生气体过多,但其实这是因为便秘等问题,导致气体在肠道内流通不畅。或者是因为他们所产生的气体量并不多,只是放屁次数比较频繁,每次排放气体量较少而已。Kashyap说:“如果你为此去改变饮食习惯,那么不仅问题会得不到解决,而且还会对自身产生危害。“
当然也有例外,如果你确实气体产生量较多,或肚子胀气,这预示着你的身体很可能出现了某种问题,如乳糖不耐受等,这时候,你最好去看看医生。
翻译:尉艳华
· · · · · · · · · · · · · · · · · · · · · · · · · · · · · · · · · · · · · · · · · · · · · · · · · · · · · · · · · ·
想要获取更多有意思的内容,请移步界面网站首页(http://www.jiemian.com/),并在微博上调戏萌萌哒歪楼菌→【歪楼-Viral】(请猛戳这里)。
你也可以关注乐趣频道的微信公众号【歪楼】:esay1414





评论